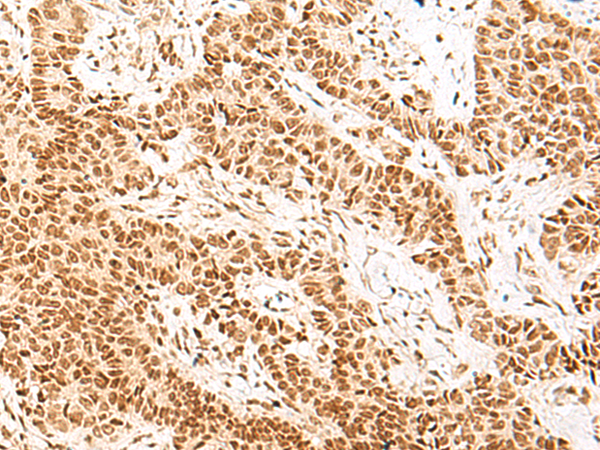

中文名稱 : 兔抗NHP2多克隆抗體
英文名稱 : Anti-NHP2 rabbit polyclonal antibody
別 名 : NHP2 ribonucleoprotein; DKCB2; NHP2P; NOLA2
儲(chǔ) 存 : 冷凍(-20℃)
抗 原 : NHP2
宿 主 : Rabbit
反應(yīng)種屬 : Human, Mouse
相關(guān)類別 : 一抗
標(biāo) 記 物 : Unconjugate
克隆類型 : rabbit polyclonal
技術(shù)規(guī)格
|
Background: |
This gene is a member of the H/ACA snoRNPs (small nucleolar ribonucleoproteins) gene family. snoRNPs are involved in various aspects of rRNA processing and modification and have been classified into two families: C/D and H/ACA. The H/ACA snoRNPs also include the DKC1, NOLA1 and NOLA3 proteins. These four H/ACA snoRNP proteins localize to the dense fibrillar components of nucleoli and to coiled (Cajal) bodies in the nucleus. Both 18S rRNA production and rRNA pseudouridylation are impaired if any one of the four proteins is depleted. The four H/ACA snoRNP proteins are also components of the telomerase complex. This gene encodes a protein related to Saccharomyces cerevisiae Nhp2p. Alternative splicing results in multiple transcript variants. |
|
Applications: |
ELISA, IHC |
|
Name of antibody: |
NHP2 |
|
Immunogen: |
Fusion protein of human NHP2 |
|
Full name: |
NHP2 ribonucleoprotein |
|
Synonyms: |
DKCB2; NHP2P; NOLA2 |
|
SwissProt: |
Q9NX24 |
|
ELISA Recommended dilution: |
5000-10000 |
|
IHC positive control: |
Human breast cancer |
|
IHC Recommend dilution: |
10-50 |

購物車
幫助
021-54845833/15800441009
